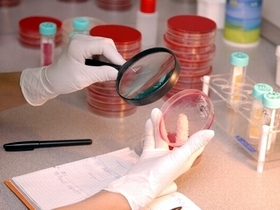

Virusološke analize od sada i u Prokuplju
Mikrobiološka laboratorija Opšte bolnice „Dr Aleksa Savić“ otpočela je sa radom virusoloških analiza koje do sada nisu obavljane u ovoj ustanovi.
U pitanju su analize hepatitisa A, B i C, HIV virusa, citomegalovirusa, Ebstajn-Barovog virusa, toksoplazmoze, Clostridium difficile – toksina A i B i analiza virusa Lajmske bolesti.
Na ovaj način biće omogućeno svim Topličanima da urade osnovne virusološke analize, zbog kojih su sada morali da putuju u Niš.
Biljana Roganović
Povezane teme
Slični tekstovi
Komentari
1Pošalji komentar
Molimo vas da se u komentarima držite teme teksta. Redakcija Južnih vesti zadržava pravo da – ukoliko ih proceni kao neumesne – skrati ili ne objavi komentare koji sadrže osvrte na nečiju ličnost i privatan život, uvrede na račun autora teksta i/ili članova redakcije kao i bilo kakvu pretnju, uvredu, nepristojan rečnik, govor mržnje, rasne i nacionalne uvrede ili bilo kakav nezakonit sadržaj.
Komentare pisane verzalom i linkove na druge sajtove ne objavljujemo. Južne vesti nemaju nikakvu obavezu obrazlaganja odluka vezanih za komentare i njihovo objavljivanje.
Mišljenja iznešena u komentarima su privatno mišljenje autora komentara i ne odražavaju stavove redakcije Južnih vesti.
Smatra se da ste slanjem komentara potvrdili saglasnost sa gore navedenim pravilima.
Administratorima Južnih vesti se možete obratiti preko Kontakt stranice.




Pa mozete i zgradu VMA da dobijete dzaba vam Najzalosnije je da nemamo kvalitetan kadar da radi sa istom opremom Mozete mi lupati negative Ali od svih doktora u PK to zvanje polovina i vise nezasluzuj